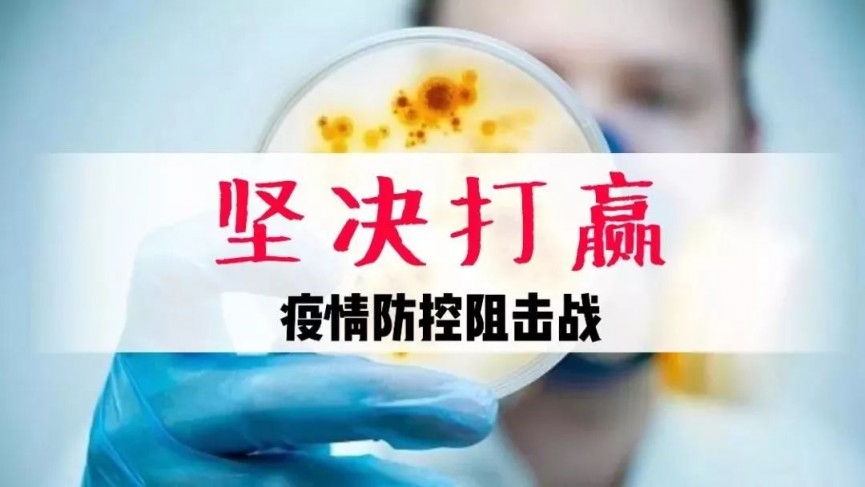

据吉林省政府新闻办官方微信消息,5月10日,按照国家新冠肺炎疫情分区分级标准,吉林省将舒兰市风险等级由中风险调整为高风险。出现本地疫情后,省市县三级第一时间采取果断措施,全力防止疫情扩散蔓延。具体措施包括:对所有社区、村(屯)实行封闭管理,城区以居民小区为单位,各小区原则上封闭管控等。
通报指,5月7日,舒兰市确诊1例新冠肺炎本土病例。5月9日,新增新冠肺炎本土确诊病例11例。5月10日,按照国家新冠肺炎疫情分区分级标准,吉林省将舒兰市风险等级由中风险调整为高风险。出现本地疫情后,省市县三级第一时间采取果断措施,全力防止疫情扩散蔓延。
全面开展流行病学调查。在省、市专家组的指导帮助下,利用大数据、电话、入户等多种方式开展流调,详细调查确诊病例及密接人员行动轨迹,果断采取措施,第一时间封锁病例工作单位和所在社区单元,全面开展消杀。
实行提级管理。采取“外防输出,内防扩散”的管控措施,形成县城、县域两个安全防控圈,除运输农用物资和生活物资外,其他车辆和人员严格限制通行。建立“五位一体”包保责任制,落实网格化管理,对所有社区、村(屯)实行封闭管理,对所有在舒人员开展地毯式排查,对国内重点地区和境外来(返)舒人员进行细致筛查,暂停营业场所,强化药店、诊所、发热门诊管理,做好疾控、医护、转运等人员防护,切实切断传播途径。
城区以居民小区为单位,各小区原则上封闭管控,每个小区仅保留一个出入通道(确保消防、救护等特种车辆通行),外来人员及车辆一律禁止进入。乡村以自然屯为单位,所有路口原则上设置专人看护,严控人员外出,每户家庭可指派1名家庭成员外出采购生活物资,如极特殊情况需出村(屯)的,必须由村委会开具证明,方可出行。落实出租房屋管理主体责任,房主和承租人要及时向乡镇(街道)、村(社区)报告,加强对承租人员的管控,如出租房发生疫情而未及时报告,将依法追究房屋出租主体单位或个人的责任。
开复工企业要严格按照《吉林省机关企事业单位复工疫情防控指南(1.0版)》要求,落实好开复工的各项疫情防控和安全措施;已经复学的高三、初三年级学生恢复网上授课模式,停课不停学。卫生健康、市场监管、工信、公安、交通等部门充分发挥联防联控机制作用,抓实落细各项防控措施,确保校园绝对安全。
城乡居民除工作、生活、就医等必要需求外,原则上不出门、不上街、不串门、不聚集。暂时关停公共服务及娱乐场所,主要包括室内体育场馆、景区景点、旅行社、电影院、游乐场、图书馆、网吧、酒吧、KTV、棋牌室、麻将馆、台球厅、浴池等。全市城区、各乡镇(街道)和村屯(社区)内停止一切聚集活动。全市餐饮单位原则上禁止堂食(可提供外卖服务)。严格落实隔离管控措施,核酸检测做到应检尽检。
此外,在严格落实疫情防控措施的基础上,进一步保障疫情期间居民日常生活需要,进一步确保春耕农资供应充足。

 您的当前位置:
您的当前位置:

